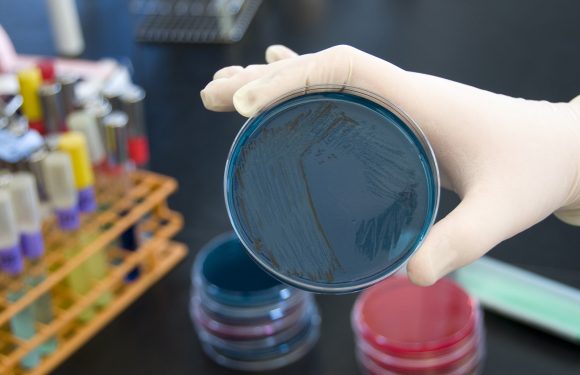
La salmonelle est impliquée dans beaucoup de scandales sanitaires — voici ce qu’il faut savoir sur cette bactérie

«Opération de communication» : Chantal Jouanno révèle les coulisses du grand débat national
OnChantal Jouanno, alors candidate aux élections régionales, tient une conférence de presse, le 28 octobre 2015 à Paris (image d’illustration). A peine nommée pour diriger le grand débat national, l’ex-ministre se retirait après une polémique autour de son salaire. Preuves à l’appui,…